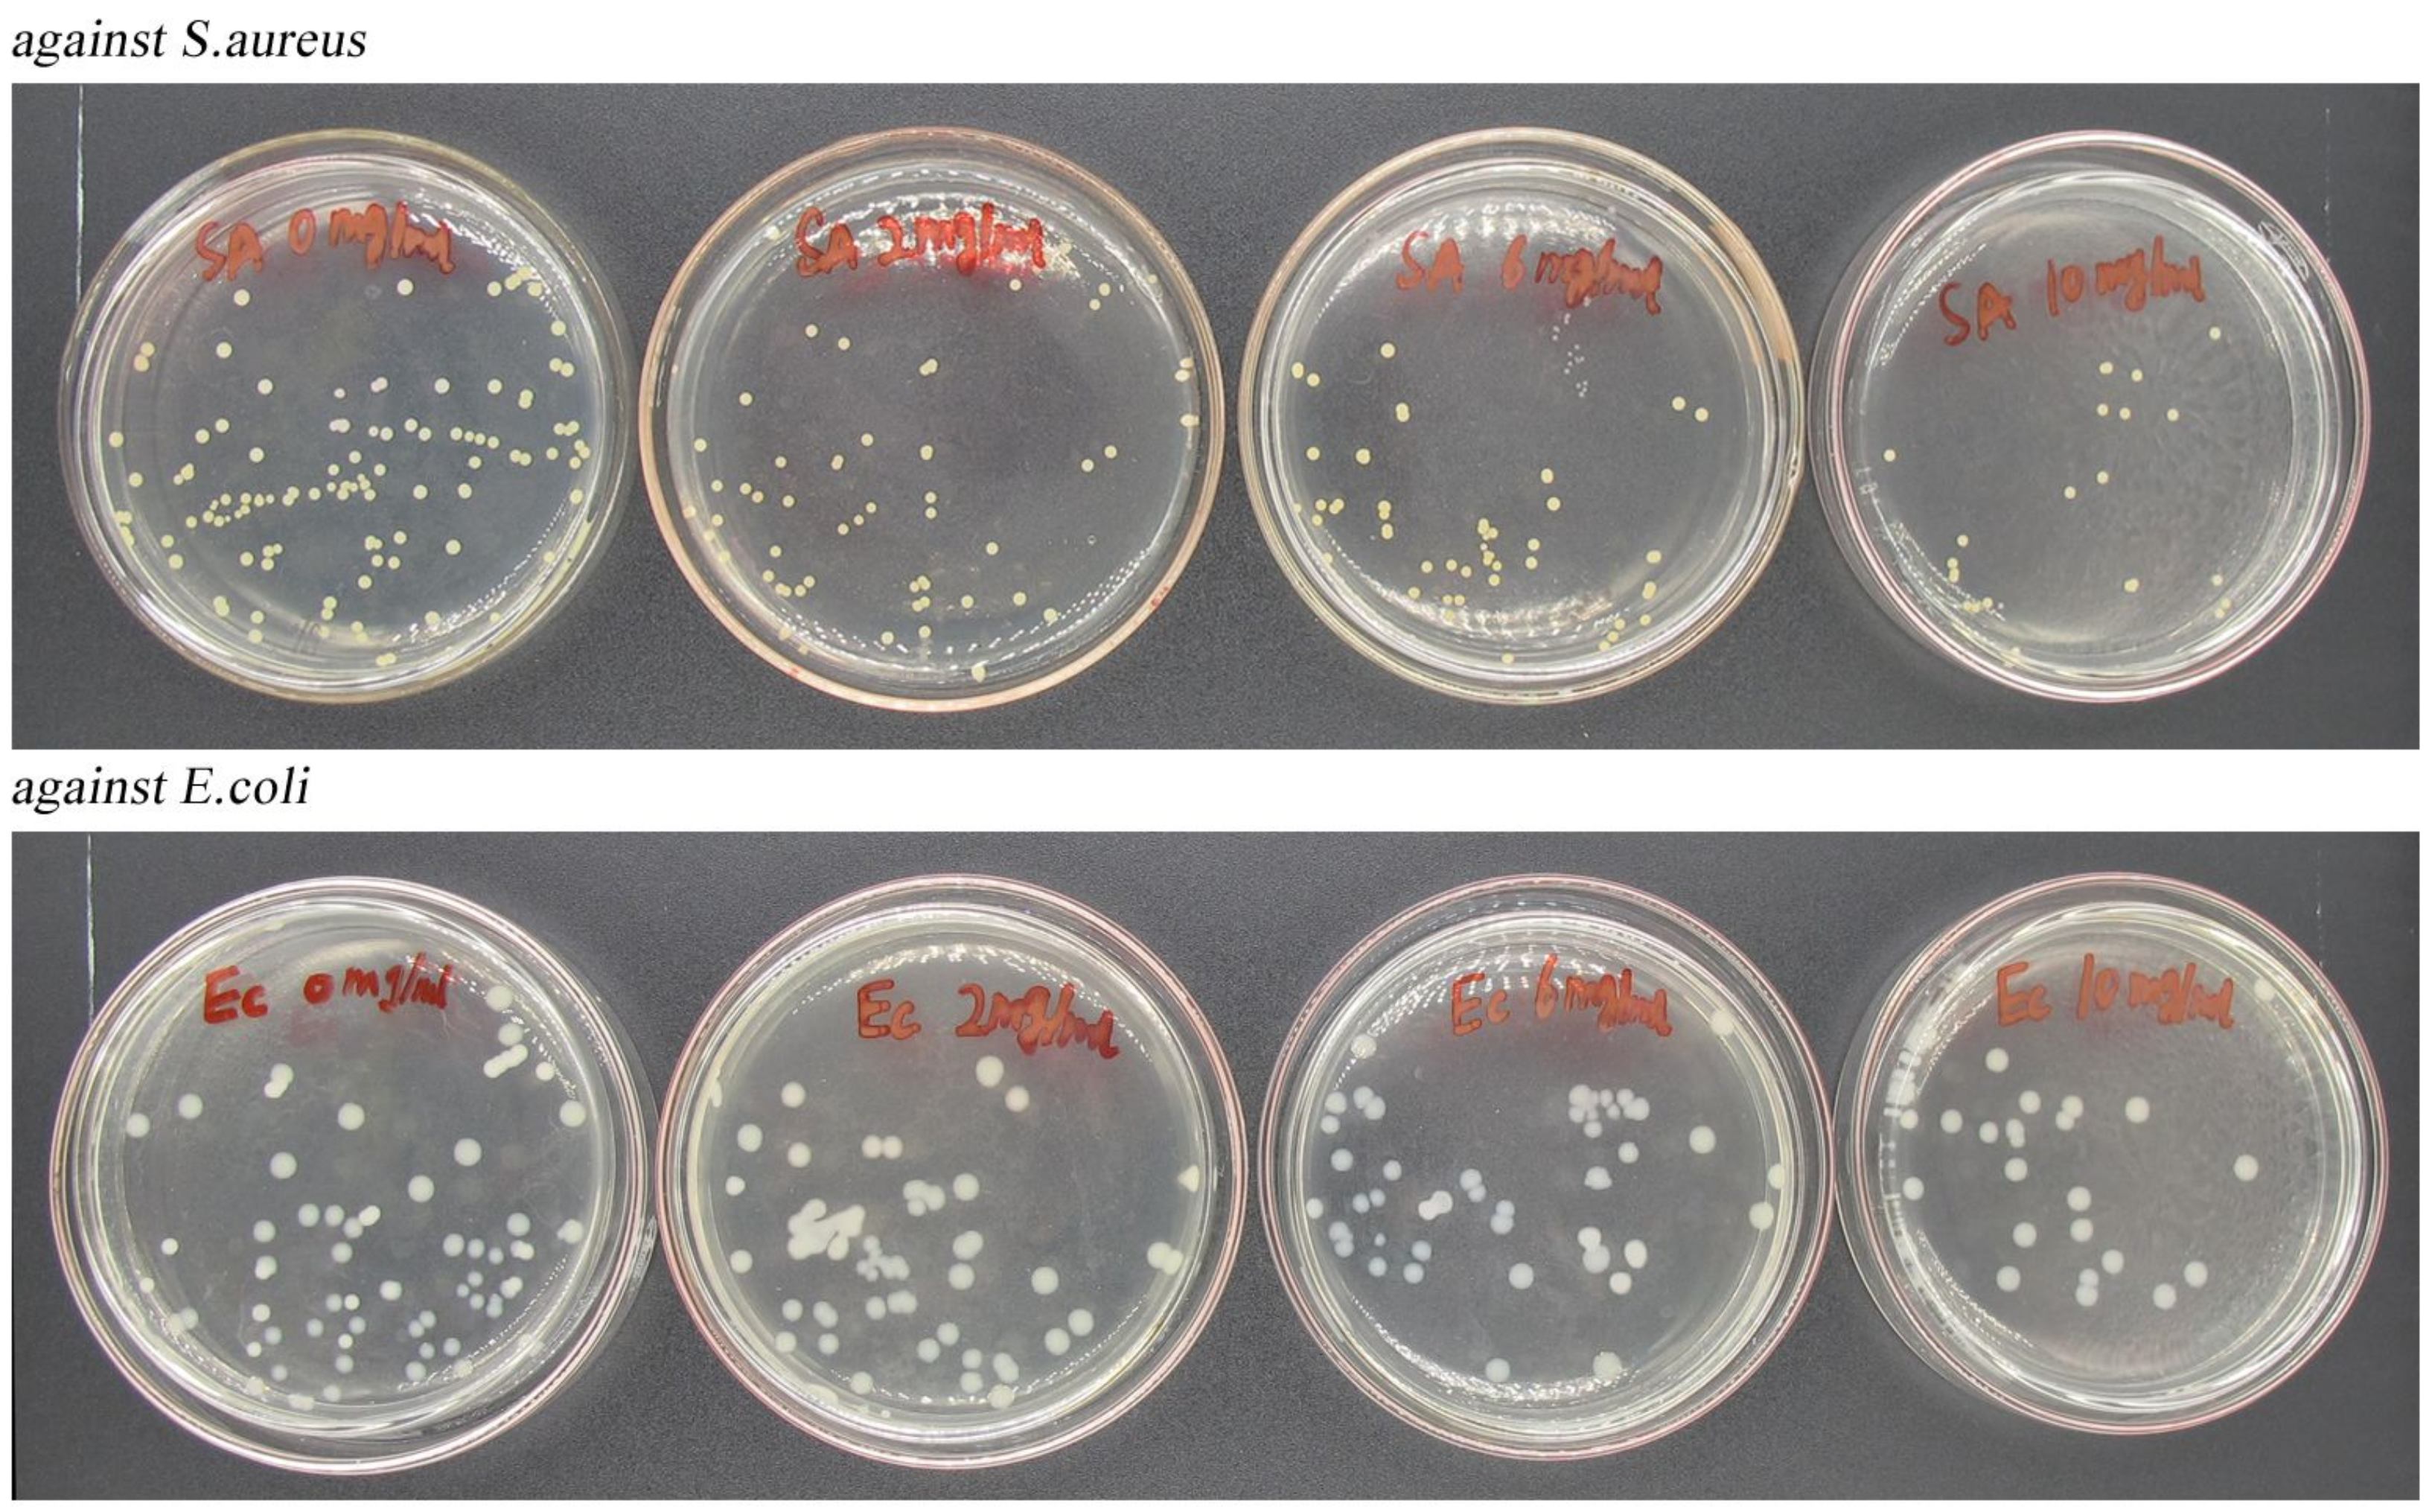
Nanomaterials 12 02189 g013

Preparation and Characterization of Carvacrol-Loaded Caseinate/Zein-Composite Nanoparticles Using the Anti-Solvent Precipitation Method
Abstract
:1. Introduction
2. Materials and Methods
2.1. Materials
2.2. Preparation of CA Loaded Composite Nanoparticles
2.3. Characterization
2.3.1. FT-IR Analysis
2.3.2. Measurement of Encapsulation Efficiency (EE)
2.3.3. Size and Zeta Potential of Composite Nanoparticles
2.3.4. Redispersibility of Composite Nanoparticles
2.3.5. Storage Stability of Composite Nanoparticles
2.3.6. Field-Emission Scanning-Electron Microscope (FE-SEM)
2.3.7. Differential-Scanning Calorimetry (DSC) and Thermal-Gravimetric Analysis (TGA)
2.3.8. Antioxidant Properties of Composite Nanoparticles
2.3.9. Evaluation of Antimicrobial Activity
2.3.10. Assay of CA-Loaded Composite-Nanoparticles Application
3. Results and Discussion
3.1. FT-IR Analysis
3.2. Encapsulation Efficiency of CA-Loaded Composite Nanoparticles
3.3. Particle-Size Distribution and Zeta Potential
3.4. Redispersibility of the Composite Nanoparticles after Drying
3.5. Storage Stability of Composite Nanoparticles
3.6. FE-SEM Analysis
3.7. DSC and TGA Analysis
3.8. Oxidation-Resistance Property
3.9. Antimicrobial Activity
3.10. Assay of CA-Loaded Composite-Nanoparticles Application in Food
4. Conclusions
Author Contributions
Funding
Institutional Review Board Statement
Informed Consent Statement
Data Availability Statement
Conflicts of Interest
References
- Yang, J.; Wang, D.; Feng, L.; Li, D.P.; Huang, Q.R. Cinnamon essential oil Pickering emulsion stabilized by zein-pectin composite nanoparticles: Characterization, antimicrobial effect and advantages in storage application. Int. J. Biol. Macromol. 2020, 148, 1280–1289. [Google Scholar]
- Liu, F.; Jin, P.P.; Sun, Z.L.; Du, L.H.; Wang, D.Y.; Zhao, T.; Doyle, M.P. Carvacrol oil inhibits biofilm formation and exopolysaccharide production of enterobacter cloacae. Food Control 2021, 119, 107473. [Google Scholar] [CrossRef]
- Donsì, F.; Ferrari, G. Essential oil nanoemulsions as antimicrobial agents in food. J. Biotechnol. 2016, 233, 106–120. [Google Scholar] [CrossRef] [PubMed]
- Figueroa-Lopez, K.J.; Torres-Giner, S.; Enescu, D.; Cabedo, L.; Cerqueira, M.A.; Pastrana, L.M.; Lagaron, J.M. Electrospun active biopapers of food waste derived poly(3-hydroxybutyrate-co-3-hydroxyvalerate) with short-term and long-term antimicrobial performance. Nanomaterials 2020, 10, 506. [Google Scholar] [CrossRef] [PubMed] [Green Version]
- Silva, F.T.D.; Cunha, K.F.D.; Fonseca, L.M.; Antunes, M.D.; Halal, S.L.M.E.; Fiorentin, Â.M.; Zavareze, E.D.R.; Dias, A.R.G. Action of ginger essential oil (Zingiber officinale) encapsulated in proteins ultrafine fibers on the antimicrobial control in situ. Int. J. Biol. Macromol. 2018, 118, 107–115. [Google Scholar] [CrossRef] [PubMed]
- de Carvalho, S.M.; Noronha, C.M.; Floriani, C.L.; Lino, R.C.; Rocha, G.; Bellettini, I.C.; Ogliari, P.J.; Barreto, P.L.M. Optimization of α-tocopherol loaded solid lipid nanoparticles by central composite design. Ind. Crop. Prod. 2013, 49, 278–285. [Google Scholar] [CrossRef]
- Motta Felício, I.; Limongi De Souza, R.; Oliveira Melo, C.; Gervázio Lima, K.Y.; Vasconcelos, U.; Olímpio De Moura, R.; Eleamen Oliveira, E. Development and characterization of a carvacrol nanoemulsion and evaluation of its antimicrobial activity against selected food-related pathogens. Lett. Appl. Microbiol. 2021, 72, 299–306. [Google Scholar] [CrossRef]
- Xu, T.; Gao, C.C.; Yang, Y.L.; Shen, X.C.; Huang, M.G.; Liu, S.W.; Tang, X.Z. Retention and release properties of cinnamon essential oil in antimicrobial films based on chitosan and gum arabic. Food Hydrocoll. 2018, 84, 84–92. [Google Scholar] [CrossRef]
- Yen, F.L.; Wu, Z.H.; Zeng, C.W.; Lin, L.; Lin, C. Curcumin nanoparticles improve the physicochemical properties of curcumin and effectively enhance its antioxidant and antihepatoma activities. J. Agric. Food Chem. 2010, 58, 7376–7382. [Google Scholar] [CrossRef]
- Weissmueller, N.T.; Lu, H.D.; Hurley, A.; Prud Homme, R.K. Nanocarriers from GRAS zein proteins to encapsulate hydrophobic actives. Biomacromolecules 2016, 17, 3828–3837. [Google Scholar] [CrossRef]
- Feng, S.M.; Sun, Y.X.; Wang, D.; Sun, P.L.; Shao, P. Effect of adjusting pH and chondroitin sulfate on the formation of curcumin-zein nanoparticles: Synthesis, characterization and morphology. Carbohyd. Polym. 2020, 250, 116970. [Google Scholar] [CrossRef]
- Dai, L.; Wei, Y.; Sun, C.X.; Mao, L.; McClements, D.J.; Gao, Y.X. Development of protein-polysaccharide-surfactant ternary complex particles as delivery vehicles for curcumin. Food Hydrocoll. 2018, 85, 75–85. [Google Scholar] [CrossRef]
- Wang, L.; Zhang, Y. Eugenol nanoemulsion stabilized with zein and sodium caseinate by self-assembly. J. Agric. Food Chem. 2017, 65, 2990–2998. [Google Scholar] [CrossRef]
- Kringel, D.H.; Silva, W.M.F.; Biduski, B.; Waller, S.B.; Lim, L.T.; Dias, A.R.G.; Zavareze, E.D.R. Free and encapsulated orange essential oil into a β-cyclodextrin inclusion complex and zein to delay fungal spoilage in cakes. J. Food Process. Pres. 2020, 44, e14411. [Google Scholar] [CrossRef]
- Dai, L.; Sun, C.X.; Wei, Y.; Mao, L.K.; Gao, Y.X. Characterization of Pickering emulsion gels stabilized by zein/gum arabic complex colloidal nanoparticles. Food Hydrocoll. 2018, 74, 239–248. [Google Scholar] [CrossRef]
- Hu, S.Q.; Wang, T.R.; Fernandez, M.L.; Luo, Y.C. Development of tannic acid cross-linked hollow zein nanoparticles as potential oral delivery vehicles for curcumin. Food Hydrocoll. 2016, 61, 821–831. [Google Scholar] [CrossRef]
- Liang, J.; Yan, H.; Wang, X.L.; Zhou, Y.B.; Gao, X.L.; Puligundla, P.; Wan, X.C. Encapsulation of epigallocatechin gallate in zein/chitosan nanoparticles for controlled applications in food systems. Food Chem. 2017, 231, 19–24. [Google Scholar] [CrossRef]
- Littoz, F.; McClements, D.J. Bio-mimetic approach to improving emulsion stability: Cross-linking adsorbed beet pectin layers using laccase. Food Hydrocoll. 2008, 22, 1203–1211. [Google Scholar] [CrossRef]
- Hamelian, M.; Varmira, K.; Veisi, H. Green synthesis and characterizations of gold nanoparticles using thyme and survey cytotoxic effect, antibacterial and antioxidant potential. J. Photochem. Photobiol. B Biol. 2018, 184, 71–79. [Google Scholar] [CrossRef]
- Chang, C.; Wang, T.R.; Hu, Q.B.; Yang, C. Zein/caseinate/pectin complex nanoparticles: Formation and characterization. Int. J. Biol. Macromol. 2017, 104, 117–124. [Google Scholar] [CrossRef]
- Veneranda, M.; Hu, Q.; Wang, T.; Luo, Y.; Castro, K.; Madariaga, J.M. Formation and characterization of zein-caseinate-pectin complex nanoparticles for encapsulation of eugenol. LWT-Food Sci. Technol. 2018, 89, 596–603. [Google Scholar] [CrossRef]
- Zhang, H.; Fu, Y.; Xu, Y.J.; Niu, F.G.; Li, Z.Y.; Ba, C.J.; Jin, B.; Chen, G.W.; Li, X.M. One-step assembly of zein/caseinate/alginate nanoparticles for encapsulation and improved bioaccessibility of propolis. Food Funct. 2019, 10, 635–645. [Google Scholar] [CrossRef]
- Liu, Y.X.; Liang, Q.F.; Liu, X.Q.; Raza, H.; Ma, H.; Ren, X.F. Treatment with ultrasound improves the encapsulation efficiency of resveratrol in zein-gum arabic complex coacervates. Food Sci. Technol. 2022, 153, 112331. [Google Scholar] [CrossRef]
- Gali, L.; Bedjou, F.; Ferrari, G.; Donsì, F. Formulation and characterization of zein/gum arabic nanoparticles for the encapsulation of a rutin-rich extract from ruta chalepensis. Food Chem. 2022, 367, 129982. [Google Scholar] [CrossRef]
- Chen, H.Q.; Zhang, Y.; Zhong, Q.X. Physical and antimicrobial properties of spray-dried zein–casein nanocapsules with co-encapsulated eugenol and thymol. J. Food Eng. 2015, 144, 93–102. [Google Scholar] [CrossRef]
- Luis, A.I.S.; Campos, E.V.R.; de Oliveira, J.L.; Guilger-Casagrande, M.; de Lima, R.; Castanha, R.F.; de Castro, V.L.S.S.; Fraceto, L.F. Zein nanoparticles impregnated with eugenol and garlic essential oils for treating fish pathogens. ACS Omega 2020, 5, 15557–15566. [Google Scholar] [CrossRef]
- Patel, A.R.; Bouwens, E.C.; Velikov, K.P. Sodium caseinate stabilized zein colloidal particles. J. Agric. Food Chem. 2010, 58, 12497–12503. [Google Scholar] [CrossRef]
- Pourhossein, A.; Rafizadeh, M.; Chen, P. Stimuli-responsive zein-based nanoparticles as a potential carrier for ellipticine: Synthesis, release, and in vitro delivery. Polym. Advan. Technol. 2020, 31, 2007–2019. [Google Scholar] [CrossRef]
- Beirão-da-Costa, S.; Duarte, C.; Bourbon, A.I.; Pinheiro, A.C.; Januário, M.I.N.; Vicente, A.A.; Beirão-da-Costa, M.L.; Delgadillo, I. Inulin potential for encapsulation and controlled delivery of oregano essential oil. Food Hydrocoll. 2013, 33, 199–206. [Google Scholar] [CrossRef] [Green Version]
- Torres-Giner, S.; Lagaron, J.M. Zein-based ultrathin fibers containing ceramic nanofillers obtained by electrospinning. I. Morphology and thermal properties. J. Appl. Polym. Sci. 2010, 118, 778–789. [Google Scholar] [CrossRef]
- Pereira, R.N.; Souza, B.W.S.; Cerqueira, M.A.; Teixeira, J.A.; Vicente, A.A. Effects of electric fields on protein unfolding and aggregation: Influence on edible films formation. Biomacromolecules 2010, 11, 2912–2918. [Google Scholar] [CrossRef] [PubMed] [Green Version]
- Mocanu, A.M.; Moldoveanu, C.; Odochian, L.; Paius, C.M.; Apostolescu, N.; Neculau, R. Study on the thermal behavior of casein under nitrogen and air atmosphere by means of the TG-FTIR technique. Thermochim. Acta 2012, 546, 120–126. [Google Scholar] [CrossRef]
- Rodríguez-Félix, F.; Del-Toro-Sánchez, C.L.; Tapia-Hernández, J.A. A new design for obtaining of white zein micro- and nanoparticles powder: Antisolvent-dialysis method. Food Sci. Biotechnol. 2020, 29, 619–629. [Google Scholar] [CrossRef] [PubMed]
- Shao, Y.; Wu, C.H.; Wu, T.T.; Li, Y.; Chen, S.G.; Yuan, C.H.; Hu, Y.Q. Eugenol-chitosan nanoemulsions by ultrasound-mediated emulsification: Formulation, characterization and antimicrobial activity. Carbohyd. Polym. 2018, 193, 144–152. [Google Scholar] [CrossRef]
- Wang, L.; Heising, J.; Fogliano, V.; Dekker, M. Fat content and storage conditions are key factors on the partitioning and activity of carvacrol in antimicrobial packaging. Food Packag. Shelf Life 2020, 24, 100500. [Google Scholar] [CrossRef]
- Sara, A.B.; Mattijs, J.F.; Henk, P.H.; Frans, V.K.; Edwin, J.A.V. Inhibition of Salmonella enterica serotype Enteritidis on agar and raw chicken by carvacrol vapour. Int. J. Food Microbiol. 2007, 119, 346–350. [Google Scholar]
- He, W.Q.; Wang, Z.Y.; Hou, C.S.; Huang, X.; Yi, B.; Yang, Y.; Zheng, W.R.; Zhao, X.; Yao, X. Mucus-inspired supramolecular adhesives with oil-regulated molecular configurations and long-lasting antibacterial properties. ACS Appl. Mater. Interfaces 2020, 12, 16877–16886. [Google Scholar] [CrossRef]

| Zein/SC Mass Ratios | 4:1 | 2:1 | 1:1 | 1:2 |
|---|---|---|---|---|
| Particle size/nm | 235.6 ± 5 | 150.6 ± 0.5 | 148.8 ± 2.5 | 139.6 ± 2.3 |
| PDI | 0.17 ± 0.005 | 0.112 ± 0.01 | 0.126 ± 0.02 | 0.117 ± 0.004 |
Publisher’s Note: MDPI stays neutral with regard to jurisdictional claims in published maps and institutional affiliations. |
© 2022 by the authors. Licensee MDPI, Basel, Switzerland. This article is an open access article distributed under the terms and conditions of the Creative Commons Attribution (CC BY) license (https://creativecommons.org/licenses/by/4.0/).
Share and Cite
Zheng, H.; Wang, J.; Zhang, Y.; Xv, Q.; Zeng, Q.; Wang, J. Preparation and Characterization of Carvacrol-Loaded Caseinate/Zein-Composite Nanoparticles Using the Anti-Solvent Precipitation Method. Nanomaterials 2022, 12, 2189. https://doi.org/10.3390/nano12132189
Zheng H, Wang J, Zhang Y, Xv Q, Zeng Q, Wang J. Preparation and Characterization of Carvacrol-Loaded Caseinate/Zein-Composite Nanoparticles Using the Anti-Solvent Precipitation Method. Nanomaterials. 2022; 12(13):2189. https://doi.org/10.3390/nano12132189
Chicago/Turabian StyleZheng, Huaming, Jiangli Wang, Yiqiang Zhang, Quanwei Xv, Qiaohui Zeng, and Jingjing Wang. 2022. "Preparation and Characterization of Carvacrol-Loaded Caseinate/Zein-Composite Nanoparticles Using the Anti-Solvent Precipitation Method" Nanomaterials 12, no. 13: 2189. https://doi.org/10.3390/nano12132189
APA StyleZheng, H., Wang, J., Zhang, Y., Xv, Q., Zeng, Q., & Wang, J. (2022). Preparation and Characterization of Carvacrol-Loaded Caseinate/Zein-Composite Nanoparticles Using the Anti-Solvent Precipitation Method. Nanomaterials, 12(13), 2189. https://doi.org/10.3390/nano12132189

